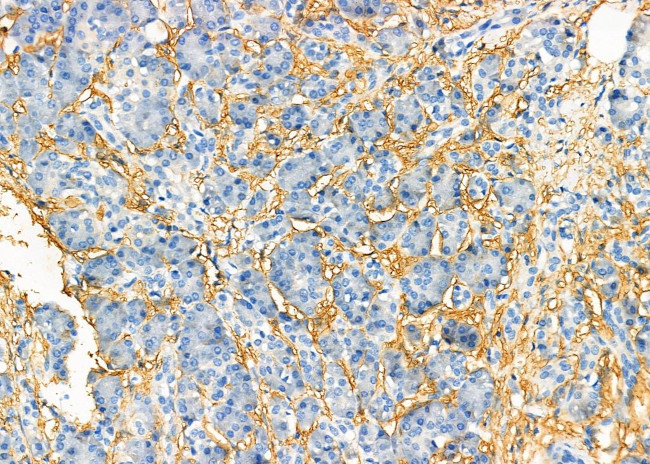
Cystatin 8 Antibody in Immunohistochemistry (Paraffin) (IHC (P))

Search
Invitrogen
Cystatin 8 Polyclonal Antibody
{{$productOrderCtrl.translations['antibody.pdp.commerceCard.promotion.promotions']}}
{{$productOrderCtrl.translations['antibody.pdp.commerceCard.promotion.viewpromo']}}
{{$productOrderCtrl.translations['antibody.pdp.commerceCard.promotion.promocode']}}: {{promo.promoCode}} {{promo.promoTitle}} {{promo.promoDescription}}. {{$productOrderCtrl.translations['antibody.pdp.commerceCard.promotion.learnmore']}}
图: 1 / 3
Cystatin 8 Antibody (PA5-102396) in IHC (P)



Please note: We are reviewing Western blot images included in the antibody testing data in our catalog, including those provided by third parties. Unless expressly labeled or annotated as “raw-unedited”, Western blot images included in the antibody testing data in our catalog may have been edited, optimized or otherwise adjusted for presentation.
产品信息
PA5-102396
种属反应
宿主/亚型
分类
类型
抗原
偶联物
形式
浓度
规格
纯化类型
保存液
内含物
保存条件
运输条件
RRID
产品详细信息
Antibody detects endogenous levels of total CST8.
靶标信息
The cystatin superfamily is a well-established family of cysteine protease inhibitors. All true cystatins inhibit cysteine peptidases of the papain family, such as cathepsins, while some also inhibit legumain family enzymes. The CRES (cystatin-related epididymal spermatogenic) protein defines a new subgroup in the family 2 cystatins of the cystatin superfamily. CRES proteins lack two of the three consensus sites necessary for the cystatin inhibition of C1 cysteine proteases. They are also preferentially expressed in postmeiotic germ cells, the proximal caput epididymidis, and anterior pituitary gonadotrophs. Therefore, CRES proteins may perform unique and tissue-specific functions in the reproductive and neuroendocrine systems. As a member of the CRES subfamily, Cystatin 8 is a 142 amino acid protein that is expressed in the proximal caput region of the epididymis, where it performs a specialized role during sperm development and maturation.
仅用于科研。不用于诊断过程。未经明确授权不得转售。
篇参考文献 (0)
生物信息学
蛋白别名: CRES; CST 8; cystatin 8 (cystatin-related epididymal specific); cystatin 8 (cystatin-related epididymal spermatogenic); Cystatin-8; Cystatin-related epididymal spermatogenic protein; Cystatin-related epididymal-specific protein; epididymis secretory sperm binding protein
基因别名: CRES; Cst-rs1; CST8; CTES5
UniProt ID: (Rat) O88969, (Mouse) P32766
Entrez Gene ID: (Human) 10047, (Rat) 29679, (Mouse) 13012